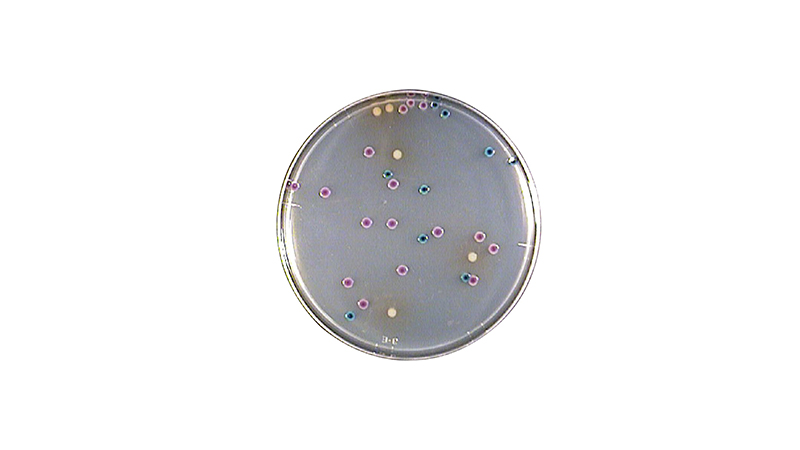
产品六.jpg

作为食品安全技术领域规模最大、人气最旺和最受欢迎的行业盛会之一,CBIFS第十八届食品安全技术论坛暨太平洋食安展将于2026年4月9日-10日在苏州举办。
安科生物确认参展本次论坛,欢迎各位领导专家和客户朋友参观交流、合作洽谈!


安科生物制品(上海)有限公司
安科生物制品(上海)有限公司成立于2004年4月,由日本ELMEX株式会社投资。公司主要致力于微生物实验使用的快速检测产品的研究、开发、生产和销售。产品涉及食品、化妆品、饮料、医疗健康、第三方检测等相关行业的微生物检测。公司已通过IS09001:2015。
自成立以来,公司以“提供专业的微生物检测整体解决方案”为主题,产品涵盖了微生物样品采集至结果分析的全过程,包括各检验阶段所需的耗材、试剂盒和小型设备。拥有中日多项专利技术。公司产品大部分销往日本,东南亚及欧美等地区。通过了日本食品行业品质管理的严格考核,受到行业人员的青睐。公司的拳头产品---ST擦拭取样试剂盒系列产品占日本70%的市场率,并与知名企业签订了长期OEM合同。
电话:021-59868185
地址:上海市青浦工业园区崧华路1438号
网址:www.shankebio.com

- 扫码关注公众号 -

涂抹取样试剂盒
ELMEX的涂抹棒将检查时必须的拭子和稀释液合为一体,增添了使用的灵活性。 同时,它具备了分装功能,所以无需用移液管也可以把检液注入到培养皿和实验管中。 加长杆的设计可使ST-26系列延伸至160mm,加长手柄设计方便对远处,狭窄地,机械深部等进行擦拭取样。ELMEX的涂抹棒是一种预先制备好的环境涂抹系统。
食品、饮料、制药及化妆品行业的表面采样。

均质袋
1.取样均质袋均采用高强度复合材质,在均质器的强力拍击下也不会破损。产品经辐照灭菌,包装卫生安全。
2.AKJ系列均质袋具有侧边魔术撕口设计,根据样液多少可在任意处撕开,方便均质后取样且不会污染移液枪枪体。
3.PX0020设有下拉撕口设计,根据样液多少随意撕拉,方便均质后取样且不会污染移液枪枪体。
4.使用高密度过滤网,能有效地过滤食物残渣。使培养后的菌落计数不受干扰。适用于快速分析方法,样品经过过滤后保持细菌浓度不变。
食品、饮料、制药、化妆品及三方实验室。

均质器 Pro·media SH-IIM
独创设计的粉碎板,具有硬质橡胶刀刃,粉碎能力强!粉碎耗时短,为常规方法的一半!
不锈钢材质,样品与均质器无接触,包装卫生和安全。
活动式玻璃门开关,装卸方便并带有可透视性窗,可直接隔窗观察样品的拍打状态。
该仪器可以和我公司的自动称量分注仪配合使用,即可对稀释后的样品进行充分混匀。
有手动模式和自动模式,拍打时间轻松设定。
食品、饮料、制药、化妆品及三方实验室。

无菌稀释液 MT·MV系列
在许多实验室中,通常认为由试剂直接配制缓冲液将更准确更便宜,其实这与事实不符,因为缓冲液质量与试剂纯度、试剂称量准确度、纯化水质量及其它如温度,配制容器等因素有关。该系列缓冲液在净化环境下,用高标准物质配制而成,经过辐照灭菌,适合不同量样品的稀释,部分产品可与各种装置配套使用,防止二次污染,安全、高效、操作简便。
食品、饮料、制药、化妆品及三方实验室。

运送培养基 FC-20
釆集粪便/样品保鲜/规模检验/安全卫生
粪便检验是临床三大常规检验之一,工作量大。粪便标本有异味,有的标本具有传染性病原微生物。在标本的采集、送检、处理以及检验过程中,传统的检验处理方法容易污染他人及工作台面,甚至污染检验人员;样品废弃和处理也难以严谨,对医院环境安全留有隐患。尤其是传染病暴发流行时,粪便标本的规范处理就显得更加重要。本公司研发生产的一次性运送培养基,采用更加科学、严谨、合理及人性化的设计,产品结构密闭性好,有效防止污染,便于各项操作;可提高粪便检验的阳性率和准确率;便于废弃标本的稳妥处理。是粪便检验中的新型、安全、人性化的产品。
医院及三方实验室。
大肠显色培养基
大肠菌群阳性: 大肠菌群体内有一种β- 半乳糖苷酶(P-galactosidase), β-半乳糖苷酶可以作为大肠菌群的指示酶,其催化反应底物X-GAL水解,形成5,5-dibromo-4,4-dichloro indigo,呈现浅蓝色~紫兰色。
大肠杆菌阳性:β-葡萄糖醉酸酶(β -glucuronidase) 可作为大肠杆菌的指示酶, 因为在肠道细菌中有大肠杆菌, 沙门氏菌(Salmonella)和志贺氏菌(Shigel la)中可以观察到葡萄糖酘酸酶, 并且95%的大肠杆菌
含有β-葡萄糖醉酸酶。β-葡萄糖酘酶催化MUG的水解,形成4-methylumbelliferon,其在366nm紫外线下展现荧光,在室内光照强度下可以肉眼辨识。
食品、饮料行业。




